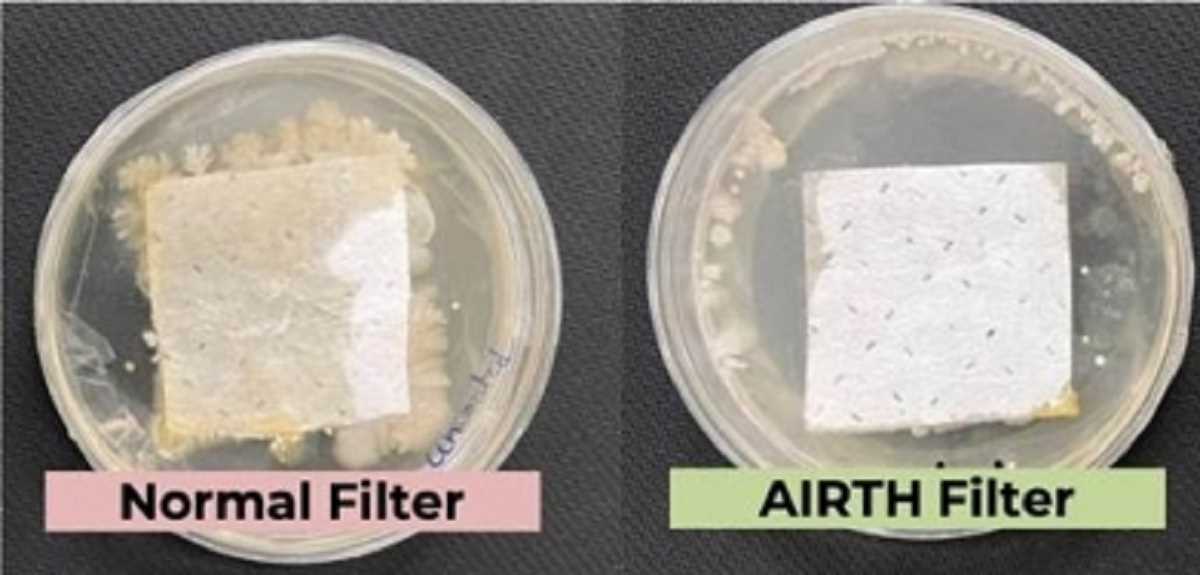
आईआईएससी ने कीटाणुओं को नष्ट करने वाले एयर फिल्टर का किया आविष्कार

Begin typing your search above and press return to search.

पूर्व छात्र संगठन में तकरार के चलते सुर्खियों में आया भारतीय विज्ञान संस्थान
बेंगलुरु। देश के शीर्ष स्तर के विश्वविद्यालयों में शुमार भारतीय विज्ञान संस्थान (आईआईएससी) के अनुसंधान व शैक्षिणक कार्यकलापों के संबंध में काफी...